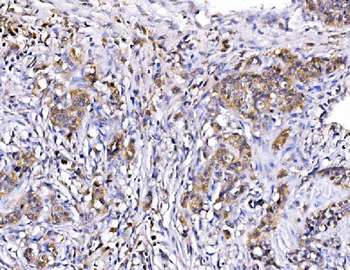
MIRO1/RHOT1 Rabbit Polyclonal Antibody
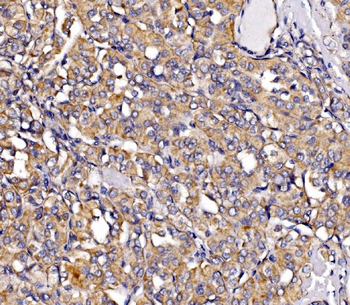
MIRO1/RHOT1 Rabbit Polyclonal Antibody

You have no items in your shopping cart.
RHOT1 Rabbit Polyclonal Antibody
Description
Research Area
Images & Validation
−| Tested Applications | IHC-P, WB |
|---|---|
| Reactivity | Human |
| Predicted Reactivity | Bovine, Canine, Equine, Guinea pig, Mouse, Rabbit, Rat, Zebrafish |
Key Properties
−| Host | Rabbit |
|---|---|
| Clonality | Polyclonal |
| Immunogen | The immunogen is a synthetic peptide directed towards the N terminal region of human RHOT1 |
| Target | RHOT1 |
| Protein Sequence | Synthetic peptide located within the following region: MKKDVRILLVGEPRVGKTSLIMSLVSEEFPEEVPPRAEEITIPADVTPER |
| Molecular Weight | 71 kDa |
| Purification | Affinity Purified |
| Conjugation | Unconjugated |
Storage & Handling
−| Storage | Maintain refrigerated at 2-8°C for up to 2 weeks. For long term storage store at -20°C in small aliquots to prevent freeze-thaw cycles. |
|---|---|
| Buffer/Preservatives | Liquid. Purified antibody supplied in 1x PBS buffer with 0.09% (w/v) sodium azide and 2% sucrose. |
| Concentration | 0.5 mg/ml |
| Expiration Date | 12 months from date of receipt. |
| Disclaimer | For research use only |
Alternative Names
−Similar Products
−MIRO1/RHOT1 Rabbit Polyclonal Antibody [orb865456]
ELISA, ICC, IF, IHC, WB
Human, Mouse, Rat
Rabbit
Polyclonal
Unconjugated
100 μgRHOT1 Rabbit Polyclonal Antibody [orb579298]
WB
Bovine, Canine, Equine, Guinea pig, Mouse, Rabbit, Rat, Zebrafish
Human
Rabbit
Polyclonal
Unconjugated
100 μlRHOT1 Rabbit Polyclonal Antibody [orb579299]
WB
Bovine, Canine, Equine, Guinea pig, Mouse, Rabbit, Rat, Zebrafish
Human
Rabbit
Polyclonal
Unconjugated
100 μl

Quality Guarantee
Explore bioreagents carefree to elevate your research. All our products are rigorously tested for performance. If a product does not perform as described on its datasheet, our scientific support team will provide expert troubleshooting, a prompt replacement, or a refund. For full details, please see our Terms & Conditions and Buying Guide. Contact us at [email protected].

25 ug of the indicated Human whole cell extracts was loaded onto a 12% SDS-PAGE gel. 1 ug/ml of the antibody was used in this experiment. There are several isoforms of RHOT1 that contain this N-terminal peptide sequence. Most isoforms are predicted to range from 66 kDa to 80 kDa.

Sample Type: Fetal Lung lysates, Antibody Dilution: 1.0 ug/ml.

Sample Tissue: Human A549 Whole Cell, Antibody Dilution: 1 ug/ml.

Sample Tissue: Human HT1080 Whole Cell, Antibody Dilution: 1 ug/ml.

Sample Type: Fetal Lung lysates, Antibody Dilution: 1.0 ug/ml.

mouse brain and human neuroblastoma

Rabbit Anti-RHOT1 Antibody, Paraffin Embedded Tissue: Human Muscle, Cellular Data: Skeletal muscle cells, Antibody Concentration: 4.0-8.0 ug/ml, Magnification: 400X.

RHOT1 was immunoprecipitated from 2 mg HEK293 Whole Cell Lysate with orb579297 with 1:200 dilution. Western blot was performed using orb579297 at 1/1000 dilution. Lane 1: Control IP in HEK293 Whole cell lysate. Lane 2: RHOT1 IP with orb579297 in HEK293 Whole cell lysate. Lane 3: Input of HEK293 Whole cell lysate.

Surface Plasmon Resonance Kinetic Characterization of Polyclonal Antibody Affinity. Purified polyclonal antibodies were immobilized on a Protein A/G coated Carterra LSA sensor chip (PAGH200M) at concentrations of 5, and 50 ug/ml in duplicate. Antibodies on the surface were exposed to interaction with peptides sequentially via microfluidic controlled flow at 333nM peptide concentration for kinetic characterization of the binders for affinity and specificity, followed by curve fitting using the Kinetics software. Kd determinations for both concentrations were averaged and results and standard deviation are shown.

WB Suggested Anti-RHOT1 antibody Titration: 1 ug/ml, Sample Type: Human A549.
Documents Download
Request a Document
Protocol Information
RHOT1 Rabbit Polyclonal Antibody (orb579297)
Participating in our Biorbyt product reviews program enables you to support fellow scientists by sharing your firsthand experience with our products.
Login to Submit a Review